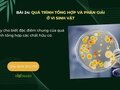
Hãy cho biết đặc điểm chung của quá trình tổng hợp các chất hữu cơ

Cho biết đặc điểm chung của các quá trình phân giải chất hữu cơ
Cho biết đặc điểm chung của các quá trình phân giải chất hữu cơ. Trả lời câu hỏi 5 trang 116 sách giáo khoa Sinh học 10 Chân trời sáng tạo

 Bộ môn: Văn
Bộ môn: Văn Lớp: 12
Lớp: 12
Cho biết đặc điểm chung của các quá trình phân giải chất hữu cơ. Trả lời câu hỏi 5 trang 116 sách giáo khoa Sinh học 10 Chân trời sáng tạo

Các chất hữu cơ đa phân tử được phân giải như thế nào? Ứng dụng của các quá trình này trong đời sống là gì? Trả lời câu hỏi 4 trang 116 sách giáo khoa Sinh học 10 CTST

Trình bày tóm tắt bằng sơ đồ hệ thống các quá trình tổng hợp các chất hữu cơ đa phân tử của vi sinh vật. Trả lời câu hỏi luyện tập 1 trang 115 sách giáo khoa Sinh học 10 CTST

Tìm thông tin liên quan về một số loại chế phẩm sinh học từ vi sinh vật. Trả lời câu hỏi 3 trang 114 sách giáo khoa Sinh học 10 Chân trời sáng tạo

Tìm thông tin liên quan tới gôm sinh học và cho biết vai trò của gôm sinh học trong đời sống con người. Trả lời câu hỏi 2 trang 114 sách giáo khoa Sinh học 10 CTST
Hãy cho biết đặc điểm chung của quá trình tổng hợp các chất hữu cơ. Trả lời câu hỏi 1 trang 114 sách giáo khoa Sinh học 10 Chân trời sáng tạo

Hãy nêu một vài ứng dụng của vi sinh vật trong thực tiễn mà em biết tùy theo kiểu dinh dưỡng của chúng. Trả lời câu hỏi 2 trang 109 sách giáo khoa Sinh học 10 CTST

Thủy triều đỏ là sự kiện thường xảy ra ở các cửa sông, cửa biển, là tên gọi chung cho hiện tượng bùng phát tảo biển nở hoa, do một số loại tảo làm xuất hiện màu đỏ hoặc nâu

Kể tên và cho biết thêm một số phương pháp khác mà em tìm hiểu được. Trả lời câu hỏi vận dụng trang 108 sách giáo khoa Sinh học 10 Chân trời sáng tạo

Hãy tìm thêm các ví dụ về một số loại vi sinh vật cho các mục tiêu nghiên cứu vi sinh vật như: Kích thước của các nhóm vi sinh vật cầu khuẩn, phẩy khuẩn, trực khuẩn,…